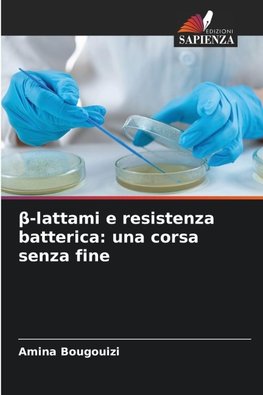
¿-lattami e resistenza batterica: una corsa senza fine

Na objednávku, dodanie 2-4 týždne
59.57 €
bežná cena: 62.70 €
O knihe
- Vydavateľstvo: Edizioni Sapienza
- Rok vydania: 2025
- Formát: Paperback
- Rozmer: 220 x 150 mm
- Jazyk: Taliansky jazyk
- ISBN: 9786209334887
Na objednávku, dodanie 2-4 týždne
59.57 €
bežná cena: 62.70 €
Generuje redakčný systém BUXUS CMS spoločnosti ui42.